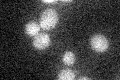
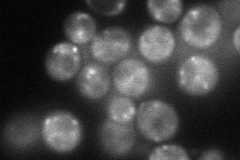
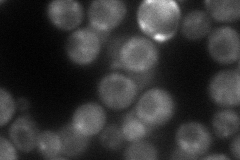

View description
Cis-golgi GTPase-activating protein (GAP) for the Rab family members Ypt1p (in vivo) and for Ypt1p, Sec4p, Ypt7p, and Ypt51p (in vitro); involved in vesicle docking and fusion
Localization:
Intensity:
Fold change:
Significance:
-
C’ GFP library in SD
below threshold16.38 -
N' NOP1pr-GFP in SD
punctate67.492 -
N' TEF2pr-mCherry in SD
punctate60.7436 -
N' NATIVEpr-GFP in SD

punctate29.259 -
N' TEF2pr-VC and Cyto-VN in SD

cytosol,punctate44.3909 -
C’ GFP library in SD+DTT

cytosol17.031.03No -
C’ GFP library in SD+H2O2

cytosol21.251.29No -
C’ GFP library in Starvation Media

cytosol22.011.34No -
C’ GFP library on the background of Pup2-DaMP

below threshold -
C’ GFP library on the background of CCT mutant

below threshold17.57941.07292No
